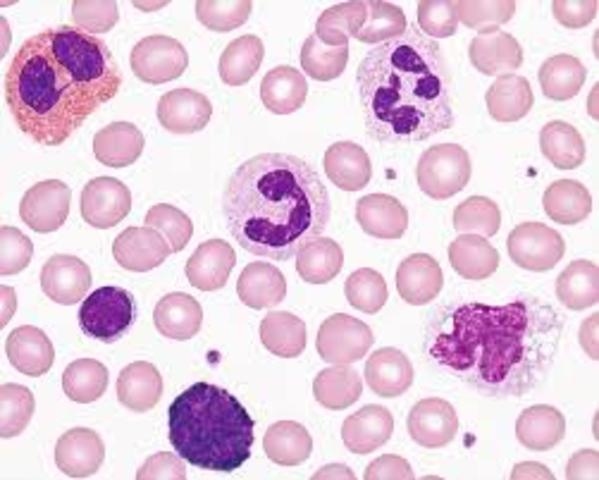
PARKER Y HOST

-
LA SANGRE ES UN FLUIDO MUY ESPECIAL
-
-
-
DESCRIBIERON CAMBIOS EN EL ASPECTO Y CONSISTENCIA DE LA SANGRE
-
PRIMERA TRANSFUSION SANGUINEA ENTRE HUMANOS
-
INICIADOR DE LA PRACTICA DE HEMATOLOGIA
-
OBSERVO QUE LAS CÉLULAS LEUCEMICAS SE ORIGINABAN EN LA MÉDULA OSEA.
-
PIONERO DE LA HEMATOLOGIA
-
SISTEMA ABO
-
CLASIFICACIÓN DE GRANULOCITOS NEUTROFILOS.
SE LE CONOCE COMO HEMOGRAMA DE ARNETH. -
Se le considera el padre de la quimioterapia, en su sentido más amplio, y sus aportes en el campo de la inmunología lo hicieron acreedor al premio Nobel.
-
PRIMERA TRANSFUSION DE SANGRE CITRATADA POR EL METODO DE AGOTE
-
GRUPOS SANGUINEOS
-
ESTABLECE UN PROCEDIMIENTO DE RECUENTO INDIVIDUALIZADO DE LAS DIFERENTES SUBPOBLACIONES LEUCOCITARIAS QUE SE CONOCE COMO HEMOGRAMA DE SCHILLING
-
-
DESARROLLARON SISTEMA RHESUS (RH)
-
INVENTAN EL COULTER A
-
UTILIZAN PRINCIPIO DE DISPERSION OPTICA TIÑENDO A GLOBULOS ROJOS Y GLOBULOS BLANCOS DE ROJO Y AZUL
-
DESCUBRIO LOS PRIMEROS ANTIGENOS LEUCOCITARIOS DEL SISTEMA HLA EN HUMANOS
-
ANOMALÍA GENÉTICA QUE HOY CONOCEMOS COMO CROMOSOMA DE PHILADELPHIA
-
INTRODUCCION DEL PROCEDIMIENTO DE PLASMAFERESIS PARA SEPARAR EL PLASMA DE LOS GLOBULOS ROJOS
-
-
MODERNOS EQUIPOS AUTOMATIZADOS, ALGUNOS DE CMF REALIZAN INMUNOTIPIFICACIONES.
-
POSIBILIDAD DE TRANSFUNDIR PRODUCTOS SANGUÍNEOS SELECCIONADOS, CONCENTRADOS DE GLÓBULOS ROJOS Y PLAQUETAS
-
DESCUBRIÓ QUE EL CROMOSOMA PHILADELPHIA ANORMAL SE DEBÍA A UNA TRANSLOCACION RECIPROCA ENTRE LOS CROMOSOMAS 9 Y 22.
-
REALIZARA LOS PRIMEROS TRASPLANTES AUTOLOGOS CON PROGENITORES DE SANGRE PERIFÉRICA
-
INTRODUJO NUEVOS MÉTODOS DE TINCION DE SANGRE.
-
A list shows items. A timeline shows sequence.
Use Timetoast to make dates, milestones, and turning points easier to understand in a clear visual format. Timetoast is a timeline maker for work, school, research, and stories.